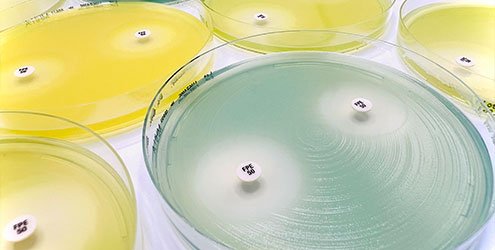

Liofilchem
Microbiology Clinical and Industrial

Liofilchem – Clinical and Industrial Microbiology Since 1983, Liofilchem has been developing and manufacturing reliable, high-quality microbiology products. The company is committed to combating the global spread of antimicrobial resistance and collaborates with leading international pharmaceutical organizations to develop diagnostic tools for antimicrobial susceptibility testing, such as MTS™ (MIC Test Strips), antibiotic discs, broth microdilution and agar dilution panels, rapid phenotypic tests, and chromogenic culture media.Liofilchem also produces dehydrated and ready-to-use culture media, biochemical identification galleries, swabs and transport media, dip-slides and contact slides, biological indicators for sterilization processes, lyophilized organisms, and various other devices for manual and phenotypic microbiology.🌍 Liofilchem products are used in clinical and industrial laboratories in more than 150 countries worldwide.🇮🇹 All manufacturing, quality control (QC), and research & development (R&D) activities are carried out at Liofilchem's headquarters across four facilities in Roseto degli Abruzzi, Italy, covering a total area of over 20,000 m². Production is conducted in strictly controlled Class A Clean Rooms, monitored for both particulate and microbiological standards, in compliance with GMP procedures.🇺🇸 Liofilchem, Inc., based in Waltham, MA (Greater Boston area), serves as the sales and distribution center for the United States, and includes an R&D laboratory.🇩🇰 Liofilchem Nordics ApS, located in Copenhagen, Denmark, is the sales and representation center for the Scandinavian region.More than 200 staff members are employed at Liofilchem. The company is certified under ISO 9001 for quality management systems and ISO 13485 for the production of in vitro diagnostic devices, in accordance with ISO, IVDR, and U.S. FDA standards.